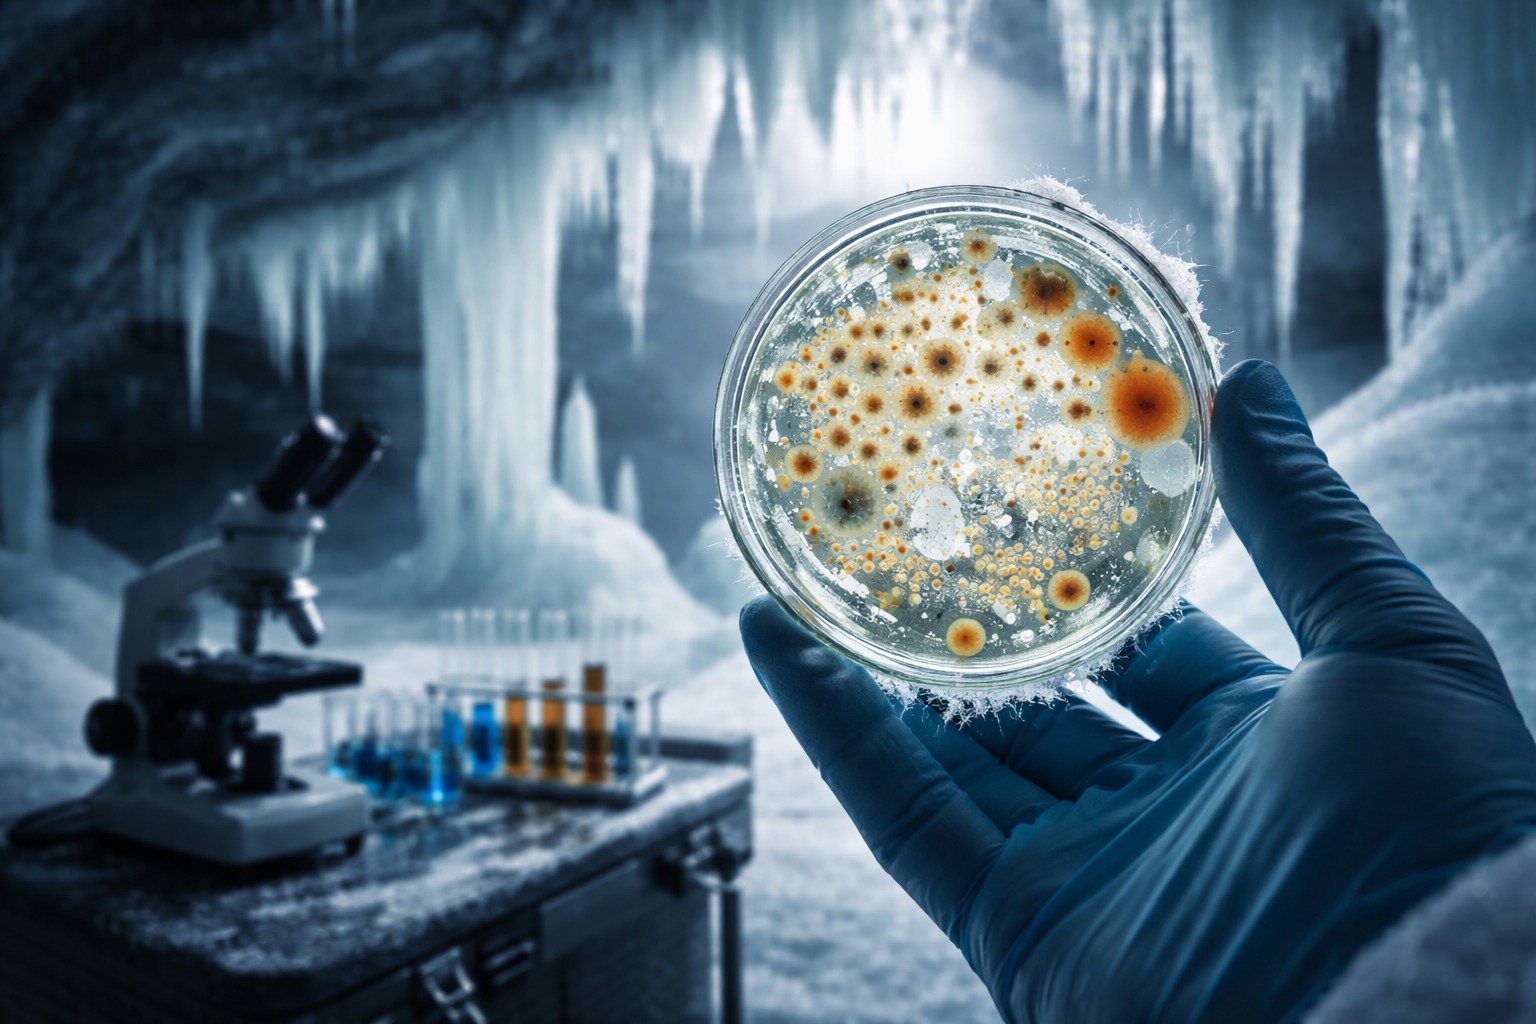
Bactéria, Bactérias, Resistência a antibióticos

Study Identifies Microorganism Preserved in Ice for Millennia with Resistance to Current Antibiotics and Raises Concerns About Melting, Genetic Transfer, and Risks to Global Public Health
Researchers have identified a bacterium that has remained frozen for about 5,000 years in an ice cave in Romania and shows resistance to multiple modern antibiotics. The finding was published in the scientific journal Frontiers in Microbiology and reignites the debate about the impacts of melting caused by climate change and the risks of exposure to ancient microorganisms.
The microorganism was located in the Scărișoara cave, in the Apuseni Mountains, considered one of the largest glacial caves in Europe.
It remained isolated from the external environment for millennia, preserved in deep layers of ice.
-
Scientists Convert Food Waste into Aviation Fuel, Successfully Test 50% Blend with Conventional Kerosene to Cut Emissions and Promote Sustainable Flights
-
OnePlus N6 Smartphone to Launch in India with 8,000mAh Battery and 45W SuperVOOC Charging, Lasting Up to Three Days
-
Scientists Plan to Release Air Bubbles Underwater to Protect Antarctica’s “Doomsday Glacier” from Melting
-
Chinese R6000 Drone Combines Airplane and Helicopter Features, Carries Up to 12 People for Multiple Missions
Even after this long period, laboratory tests demonstrated that the bacterium maintains resistance to widely used antibiotics in current medicine.
Resistance to Ancient Antibiotics Worries Researchers
Named Psychrobacter SC65A.3, the bacterium was isolated from an ice core extracted from about 25 meters deep.
Genetic sequencing revealed resistance to 28 antibiotics from ten different families, including rifampicin, vancomycin, and ciprofloxacin.
More than 100 genes linked to antimicrobial resistance were also identified.
According to scientists, the risk is not only in survival after melting but also in the possibility of genetic transfer.
These genes could be shared with current bacteria, accelerating the spread of antibiotic resistance, a problem already considered critical by the World Health Organization (WHO).
Experts warn that global warming increases exposure to previously isolated environments, such as glaciers, permafrost, and ice caves.
With the melting of these structures, ancient microorganisms could be reintroduced into modern ecosystems, without knowing exactly how they will interact with humans, animals, and other bacteria, expanding a scenario that is already seen as concerning by the scientific community.
Scientific Potential Beyond the Risks
Despite the warning, the study also points out positive possibilities. The bacterium has demonstrated the ability to produce enzymes and antimicrobial compounds capable of inhibiting the growth of current pathogens.
Genes with potential applications in the development of new antibiotics and in biotechnological processes were identified.
Researchers advocate for the constant monitoring of these regions and the controlled study of these microorganisms, both to anticipate risks and to expand scientific knowledge about forms of life preserved for millennia.
With information from Diarinho.


 Portuguese
Portuguese  Spanish
Spanish